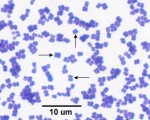

Endo agar
Endo agar (also called Endo’s medium) is a microbiological growth medium with a faint pink colour.
Purpose :
Endo agar is used to detect fecal contamination in water and dairy ...
Micrococcus luteus
Micrococcus luteus are Gram-positive, to Gram-variable, motile -non motile, that are 0.5 to 3.5 micrometers in diameter and usually arranged in tetrads or irregular clusters.
They ...

